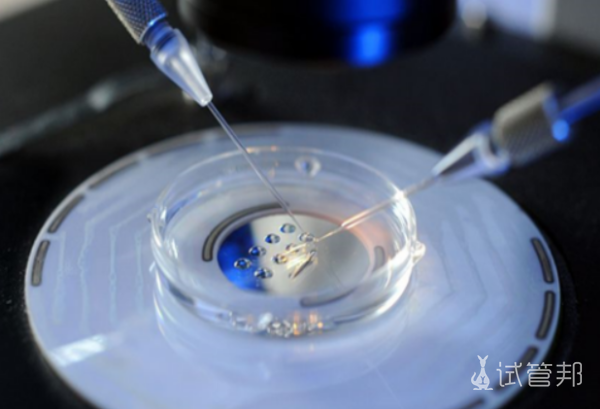
c1dddd3e2253dca492e35d368734ec80.png 胚胎移植后哪些情况暗示着床成功

胚胎移植后哪些情况暗示着床成功,鲜胚着床成功最准的信号有哪些
在辅助生殖技术中,胚胎移植是一个至关重要的环节,而移植后的着床成功与否,则直接关系到妊娠的结果。那么,胚胎移植后,哪些情况可能暗示着床成功呢?鲜胚着床成功又有哪些最准的信号呢?下面就由小编来给大家具体介绍一下,以帮助大家对此有更加详细的了解。
移植后什么表现说明成功了
胚胎移植着床后,孕妇可能出现以下症状:一是恶心呕吐,对食物气味敏感,胃部受挤压易呕吐;二是嗜睡,因体内人绒毛膜促性腺激素水平上升,需更多睡眠适应激素变化;三是尿频,胚胎长大压迫膀胱,导致储尿能力下降;四是乳房脹大,著床成功後,催產素、孕酮等激素上升,乳腺組織發育;五是腹脹腹痛,胚胎著床於子宮,引起下腹部不適。這些癥狀均為著床成功的可能跡象,但個體差異存在,需綜合判斷。
鲜胚着床成功最准的信号有哪些呢
1、经期推迟:正常经期延迟,可能是早期妊娠迹象。
2、乳房敏感:乳房饱满、乳头敏感或颜色略深,为着床后常见变化。
3、子宫收缩:部分女性鲜胚着床时会感到轻微子宫收缩不适。
4、着床出血:着床后,部分女性可能出现薄粉红色阴道出血。
5、身体疲乏:着床成功后,身体适应新变化,常感乏力和疲劳。
鲜胚着床后几天能测出怀孕
着床成功后最早1日可通过验血检测怀孕,尿检可能稍晚。受精卵着床时开始分泌HCG,约1天后血中浓度上升,超过25U/L为阳性,此时早孕试纸可能测出。但著床初期尿中HCG濃度低,易受尿液稀釋或試紙靈敏度影響,建議延後測試以提高準確性。盡管著床後1日血中HCG即升高,但初期數值變化輕微,參考價值有限,最佳測試時間為性生活後2周或月經推遲後。

鲜胚着床后雌二醇会升高吗
移植后着床通常伴随雌二醇水平上升。胚胎着床促使HCG值递增,刺激黄体分泌更多雌激素与孕激素,这些激素在妊娠期间持续缓升并维持高位。成功移植后,雌二醇常超200nmol/L,并可能升至1000nmol/L以上。雌二醇偏低可能预示宫外孕或流产风险,需及时就医,如B超检查确认。孕期抽血查孕酮與雌二醇宜空腹,以確保結果準確。著床成功受胚胎質量、子宮內膜厚度及激素水平等多重因素影響,故移植後應定期產檢,監測指標變化,以便及時應對異常。
“胚胎移植后哪些情况暗示着床成功,鲜胚着床成功最准的信号有哪些”的相关介绍就到这里。胚胎移植後的著床成功是一個復雜而微妙的過程,需要孕婦密切關註自身的身體變化,並在必要時尋求醫生的幫助和指導。同时,保持良好的心态和生活习惯,对于胚胎着床和妊娠的成功也至关重要。
-
试管婴儿高成功率
点击查看
-
试管婴儿费用/流程
获取详情
-
第三代试管医院
汇总收藏
-
试管婴儿补贴
领取优惠